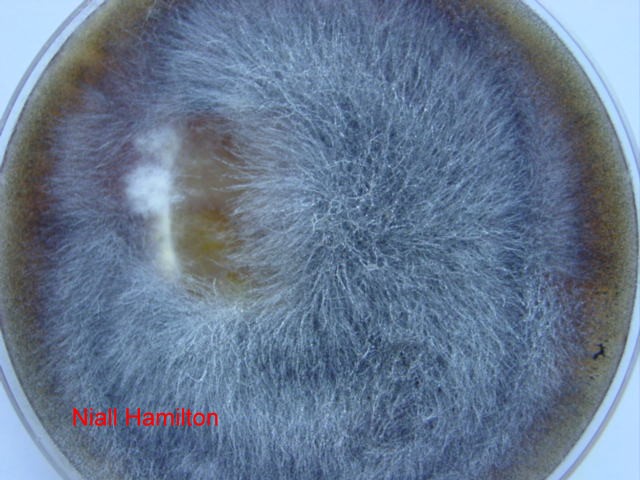
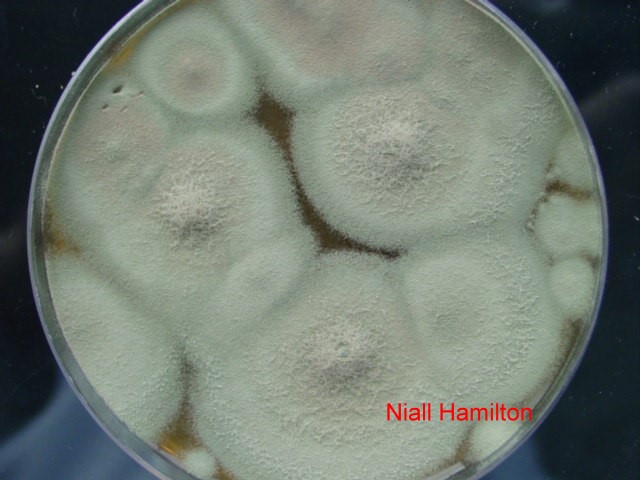
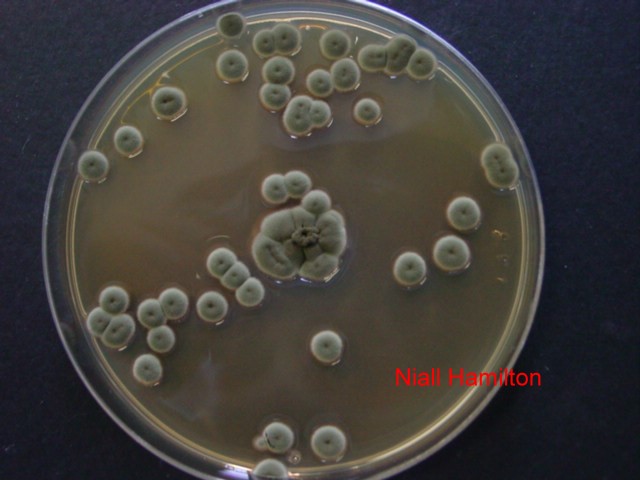

Mucor on agar
Invisible Gardens – the world of mould around us
Part One: Mouldy Bread
By Niall Hamilton, New Zealand
There is little thought spared for the mould around us; a furry piece of bread is thrown out and a dusty sill is wiped down - but both are rich microscopic landscapes.
‘Mould’ is simply a lay term for what are essentially microscopic fungi. The taxonomy of the micro-fungi can be quite daunting, this is an area of microbiology with a variety of very specific jargon; while essential for the identification of different species, it’s not really required to appreciate the vast number of shapes and forms.
I work part time as an industrial and environmental microbiologist, so I do a fair bit of identification work which draws upon both the microscopic features, and the growth characteristics of these moulds when cultured on diagnostic agars. The variety of the micro-fungi can be hard to appreciate without being able to culture and isolate the different species; so this article is designed to provide a window into that diversity, using examples of the mould in our daily life. (As this is more of an interest piece than a guide, I’ve avoided going into the technical side of the microscopy/stains used)
PLEASE NOTE: It’s important to remember that several mould species can be potential pathogens and allergens. Whenever dealing with moulds, it’s best to avoid skin contact or breathing in spores. Slides should be discarded in a disinfectant solution (e.g. 70% ethanol or any house-hold disinfectant) and surfaces should be also be cleaned with a disinfectant solution. Hands can be washed with soap and water.
The mouldy piece of bread
For the moment, we’ll ignore any green, blue or orange patches and look at the furry white and grey growths . These usually will be Rhizopus or Mucor species.
Mucor
on agar

Mucor
on agar

Rhizopus
on agar
The Mucor species have smaller sporing structures (‘sporangia’) than Rhizopus , so tends to appear hair-like or furry. The larger-spored Rhizopus species has small black pin-heads which are just visible to the naked eye. Microscopically they are similar – other than the size difference.

Rhizopus
40x

Rhizopus
400x

Rhizopus
1000x
Apart from the size difference, Rhizopus also has root-like structures (as suggested by the name) at the base of the fungal strands (‘hyphae’) which are absent in Mucor .

Rhizoids
(400x)

Mucor
400x
The green and blue patches on bread are usually Penicillium species. If that name sounds familiar, it’s probably because the antibiotic penicillin is produced by the species Penicilllium chrysogenum (formerly notatum). But that’s a separate story in itself. On agar, this mould forms blue-green colonies, and microscopically it has long brush-like structures (the name Penicillium relates to this ‘artist's’ brush’ appearance). The species here is Penicillium digitatum – commonly found on mouldy oranges. This species is instantly recognizable in the lab as the culture plates have a strong odour of rotting orange.
Penicillium
on agar

Penicillium
20x

Penicillium
1000x
Orange-red patches are less common on bread, and Chrysonilia sitophila is usually the culprit. This mould is the bane of every microbiology lab as it is fast growing and produces copious amounts of spores. As a result it ends up contaminating every plate in sight. The image below shows an agar plate on which I dotted a bit of Chrysonilia in the centre. After a week, the mould had spread beyond the borders of the plate and was creeping up the walls of the box.

Chrysonilia on agar
Dark green-brown patches are often the same mould that you’d find on a dusty window sill. In this case Cladosporium species are responsible. This mould forms a velvety green colony on agar and the spores have typical torpedo and lemon shapes. A contaminant Cladosporium in a bottle of growth medium formed the rather bizarre structure below.

Cladosporium
contaminant
Cladosporium
on
agar

Cladosporium
1000x
Comments to the author Niall Hamilton are welcomed.
Published in the January 2008 edition of Micscape.
Please report any Web problems or offer general comments to the Micscape Editor .
Micscape is the on-line monthly magazine of the Microscopy UK web site at Microscopy-UK
©
Onview.net Ltd, Microscopy-UK, and all contributors 1995
onwards. All rights reserved.
Main site is at
* please note that this link is now reduntant. See footer. * www.microscopy-uk.org.uk
with
full mirror at
* Redundant link * www.microscopy-uk.net
.